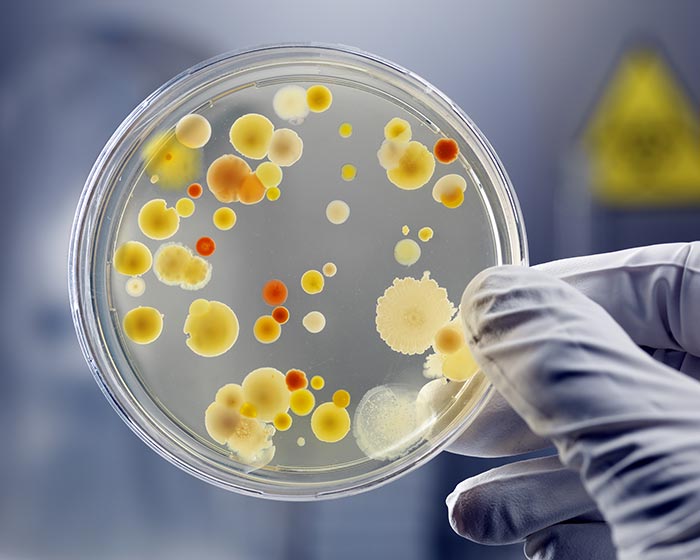
ATCC菌株

ATCC菌株是通過選擇法或克隆形成法從原代培養(yǎng)物或細胞系中獲得具有特殊性質(zhì)或標志物的培養(yǎng)物,也就是說��,ATCC菌株是用單細胞分離培養(yǎng)或通過篩選的方法��,由單細胞增殖形成的細胞群���。細胞株的特殊性質(zhì)或標志必須在整個培養(yǎng)期間始終存在���。
ATCC菌株是用單細胞分離培養(yǎng)或通過篩選的方法,由單細胞增殖形成的細胞群���。細胞株的特殊性質(zhì)或標志必須在整個培養(yǎng)期間始終存在。原代培養(yǎng)物經(jīng)傳代成功后即為細胞系���,由原先存在于原代培養(yǎng)物中的細胞世系所組成��。如果不能繼續(xù)傳代�����,或傳代次數(shù)有限�, 可稱為有限細胞系�,如可以連續(xù)培養(yǎng), 則稱為連續(xù)細胞系��,培養(yǎng)50代以上并無限培養(yǎng)下去�����。
所以細胞株是通過選擇法或克隆形成法從原代培養(yǎng)物或細胞系中獲得的具有特殊性質(zhì)或標志的培養(yǎng)細胞。從培養(yǎng)代數(shù)來講�����,可培養(yǎng)到40-50代�。細胞株的特殊性質(zhì)或標志必須在整個培養(yǎng)期間始終存在�����。對于人類腫瘤細胞��,在體外培養(yǎng)半年以上�,生長穩(wěn)定�����,并連續(xù)傳代的即可稱為連續(xù)性株或系����。